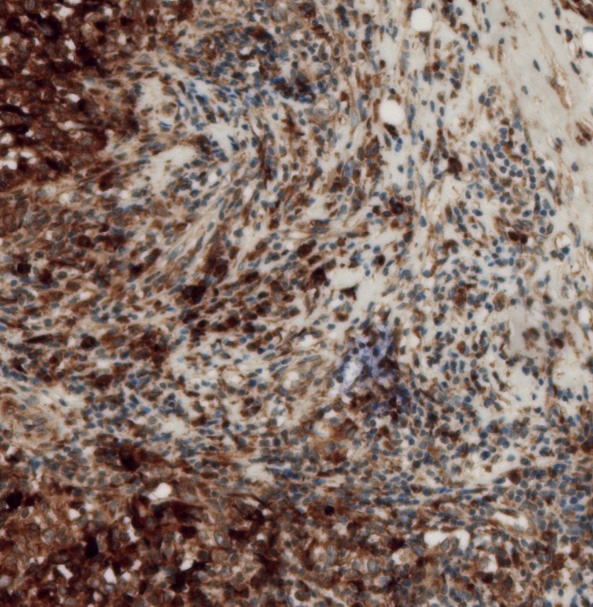

This week our undergraduate students completed then final part of their research project; presenting their research in a conference-style talk to faculty and peers.
This year we had three students in the lab, and their job was to kick start our new project on LaNt in breast cancer. Over the course of their time in the lab, Eleanor, Marian and Louiza learned how to process tissue sections for immunohistochemistry and then how to image and analyse those sections. They also turned their hand to cell culture, growing breast cancer cell lines in a dish and then studying their invasive potential in a model of cancer metastasis.

Starting a new project and getting the first taste of real lab work is challenging but they all did amazingly well. The data they generated is really impressive in quality and exciting in their implications. They’ve kick started a new direction for the lab that we think could have real value in the diagnosis and treatment of breast cancer. More on this soon.
The talks were thoroughly impressive! I genuinely enjoyed listening to them and was nothing but impressed at how the students delivered their story and the quite complex data in an accessible and accurate way.
A shout out to Dr Lee Troughton who taught the students, supervised them day to day in addition to doing his own work (and supervising Mres students too,) and really went above and beyond.
Below is the obligatory pics. Not the best quality as I didn’t want to put them off!

Eleanor

